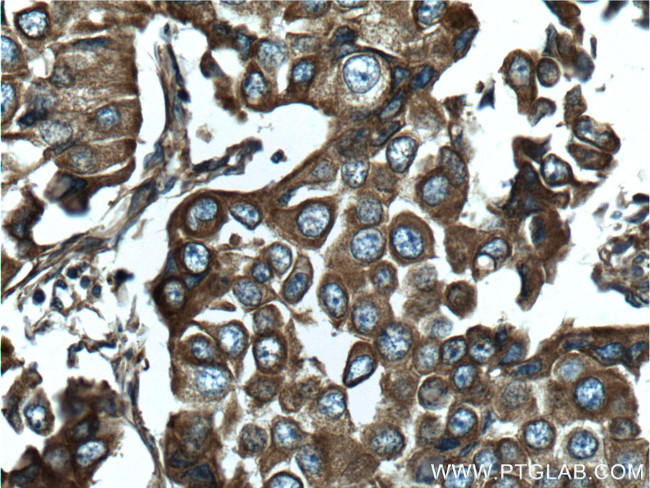
NOTCH3 Antibody in Immunohistochemistry (Paraffin) (IHC (P))
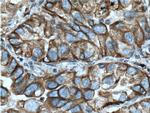
NOTCH3 Antibody in Immunohistochemistry (Paraffin) (IHC (P))

Search
Proteintech
NOTCH3 Polyclonal Antibody
{{$productOrderCtrl.translations['antibody.pdp.commerceCard.promotion.promotions']}}
{{$productOrderCtrl.translations['antibody.pdp.commerceCard.promotion.viewpromo']}}
{{$productOrderCtrl.translations['antibody.pdp.commerceCard.promotion.promocode']}}: {{promo.promoCode}} {{promo.promoTitle}} {{promo.promoDescription}}. {{$productOrderCtrl.translations['antibody.pdp.commerceCard.promotion.learnmore']}}
产品信息
55114-1-AP
种属反应
已发表种属
宿主/亚型
分类
类型
抗原
偶联物
形式
浓度
规格
纯化类型
保存液
内含物
保存条件
运输条件
产品详细信息
The antibody is specific to NOTCH3.
靶标信息
NOTCH3 is the third discovered human homologue of the Drosophilia melanogaster type I membrane protein notch. In Drosophilia, notch interaction (with its cell-bound ligands delta, serrate) establishes an intercellular signalling pathway that plays a key role in neural development. Homologues of the notch-ligands have also been identified in human. NOTCH3 functions as a receptor for membrane-bound ligands Jagged1, Jagged2, and Delta1 to regulate cell-fate determination. Mutations in NOTCH3 have been identified as the underlying cause of cerebral autosomal dominant arteriopathy with subcortical infarcts and leukoencephalopathy (CADASIL).
仅用于科研。不用于诊断过程。未经明确授权不得转售。
生物信息学
蛋白别名: Neurogenic locus notch homolog protein 3; Notch 3; Notch gene homolog 3; Notch homolog 3
基因别名: AW229011; CADASIL; CADASIL1; CASIL; hpbk; IMF2; LMNS; N3; NOTCH3
UniProt ID: (Human) Q9UM47, (Mouse) Q61982
Entrez Gene ID: (Human) 4854, (Mouse) 18131